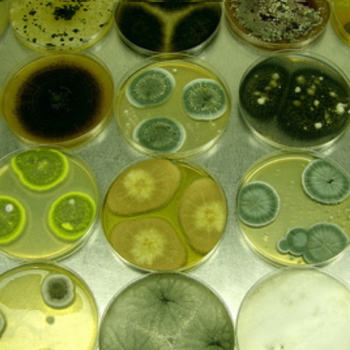

Alphabetical Index
Overview of the Microbe Herbaspirillum seropedicae is a nitrogen-fixing, β-proteobacterial endophyte belonging to the family Oxalobacteraceae. Initially described as Pseudomonas rubrisubalbicans by Leifson in 1962...
Overview of the Microbe Klebsiella pneumoniae is a Gram-negative, facultative anaerobic, rod-shaped bacterium belonging to the Enterobacteriaceae family. It is best known as an opportunistic...
Overview of the Microbe Lecanicillium longisporum, formerly classified under Verticillium lecanii, is a globally distributed, filamentous entomopathogenic fungus in the order Hypocreales and family Cordycipitaceae...
Overview of the Microbe Metarhizium anisopliae is a globally distributed, filamentous, asexual, soil-dwelling fungus classified under the family Clavicipitaceae, order Hypocreales [1]. First described by...
Overview of the Microbe Paecilomyces lilacinus is a filamentous ascomycete fungus widely found in soils and decaying organic matter around the world[1][4]. It produces fast-growing...
Overview of the Microbe Paenibacillus polymyxa is a gram-positive, rod-shaped, spore-forming bacterium commonly found in soil and the rhizosphere of plants. It thrives in diverse...
Overview of the Microbe Penicillium bilaiae (often spelled P. bilaii) is a filamentous soil fungus in the genus Penicillium, an ascomycete group known for its...
Overview of the Microbe Photorhabdus luminescens is a Gram-negative, rod-shaped bacterium in the family Morganellaceae (formerly Enterobacteriaceae) that is notable for its bioluminescence and insect-pathogenic...
Overview of the Microbe Pochonia chlamydosporia is an ascomycete fungus (Hypocreales: Clavicipitaceae) formerly known as Verticillium chlamydosporium[1]. First identified in the 1970s as a natural...
Overview of the Microbe Pseudomonas aeruginosa is a Gram‑negative, aerobic, non‑spore‑forming rod that thrives in diverse environments and causes opportunistic infections in immunocompetent and immunocompromised...
Bacillus subtilis is a robust, Gram-positive bacterium widely recognized for its adaptability and efficiency in various environments.
Overview of the Microbe Pseudomonas putida KT2440 is a non‑spore‑forming, motile, Gram‑negative bacterium isolated from soil and rhizosphere environments[1]. It harbors a ~6.18 Mbp circular chromosome...
Overview of the Microbe Pseudomonas stutzeri is a motile, rod‑shaped, non‑spore‑forming Gram‑negative bacterium first described by Lehmann and Neumann in 1896. It inhabits soil, freshwater,...
Overview of the Microbe Rhizobium leguminosarum is a Gram‑negative, non‑spore‑forming soil bacterium in the family Rhizobiaceae that nodulates a broad range of legumes, including peas,...
Bacillus subtilis is a robust, Gram-positive bacterium widely recognized for its adaptability and efficiency in various environments.